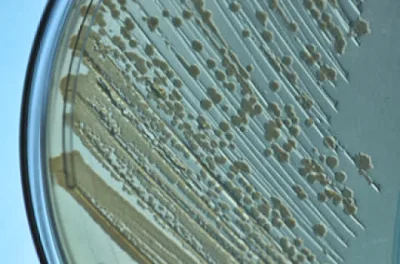

Wyss Institute file
photo of E. Coli. (Credit: Rick Groleau). In two parallel projects, researchers
have created new genomes inside the bacterium E. coli in ways that test the
limits of genetic reprogramming and open new possibilities for increasing
flexibility, productivity and safety in biotechnology.
Γενετιστές
στην Ιατρική Σχολή του Χάρβαρντ κατάφεραν να αλλάξουν τη γλώσσα στην οποία
είναι γραμμένες οι γενετικές πληροφορίες ενός βακτηρίου, ένα επίτευγμα που θα
μπορούσε να αξιοποιηθεί για την παραγωγή εντελώς νέων μορίων στη βιομηχανία
βιοτεχνολογίας, ενώ ταυτόχρονα θα μπορούσε να εμποδίσει την απόδραση γενετικά
τροποποιημένων οργανισμών.
Η
μελέτη που δημοσιεύεται στο περιοδικό Science αφορά την αλλαγή του γενετικού
κώδικα, ενός συνόλου κανόνων που χρησιμοποιούν όλοι οι οργανισμοί στη Γη για να
ερμηνεύουν τις πληροφορίες των γονιδίων.
Τα
γράμματα του βιβλίου της ζωής
Ερευνητές
κατόρθωσαν να αλλάξουν μια «τριπλέτα» γραμμάτων στο «βιβλίο» του DNA. Scientists from
Yale and Harvard have recoded the entire genome of an organism and improved a bacterium's
ability to resist viruses, a dramatic demonstration of the potential of
rewriting an organism's genetic code.
Το
μόριο του DNA είναι μια αλυσίδα που συναρμολογείται από τέσσερις διαφορετικές
χημικές βάσεις, οι οποίες είναι ουσιαστικά τα «γράμματα» στο «βιβλίο της ζωής»:
A, T, C, G. Η αλληλουχία των γραμμάτων
εξηγεί στο κύτταρο πώς να παραγάγει συγκεκριμένες πρωτεΐνες, συνδέοντας στη
σειρά διαφορετικά αμινοξέα.
Τα
κύτταρα διαβάζουν τις βάσεις αυτές ανά τρεις, με κάθε τριπλέτα (ή κωδικόνιο) να
μεταφράζεται σε ένα συγκεκριμένο αμινοξύ.
Οι
κανόνες όμως άλλαξαν στο εργαστήριο του Τζορτζ Τσερτς, καθηγητή Γενετικής στο
Χάρβαρντ. Η ομάδα του Τσερτς κατάφερε να αλλάξει το νόημα ενός συγκεκριμένου
κωδικονίου στο γονιδίωμα του κολοβακτηρίου Escherichia coli.
Συγκεκριμένα,
κατάφεραν να αλλάξουν το νόημα της τριπλέτας UAG, η οποία κανονικά λέει στο
κύτταρο πού τελειώνει κάθε γονίδιο στο μόριο του DNA. Η τριπλέτα άλλαξε
σημασία, και πλέον αντιστοιχούσε σε ένα σπάνιο αμινοξύ που δεν χρησιμοποιείται
από τους οργανισμούς στη φύση. Με άλλα λόγια, το βακτήριο παρήγαγε πρωτεΐνες
χρησιμοποιώντας ένα επιπλέον συστατικό που δεν απαντάται στη φύση.
Οι
ερευνητές αποκαλούν μάλιστα το τροποποιημένο μικρόβιο «γενετικά
επανακωδικοποιημένο οργανισμό».
Αλλαγή
κωδικονίων
Σε
μια δεύτερη μελέτη, η οποία επίσης δημοσιεύεται στο Science, η ίδια ερευνητική
ομάδα αναφέρει ότι κατάφερε να αντικαταστήσει 13 διαφορετικά κωδικόνια με νέα
κωδικόνια που είχαν την ίδια σημασία. Η τροποποίηση αυτή δεν άλλαξε τον ίδιο
τον γενετικό κώδικα, ούτε επηρέασε τη σύσταση των πρωτεϊνών που παράγει η
E.coli, δείχνει όμως ότι τα κωδικόνια του DNA είναι δυνατό να αλλάξουν με
σχετική ευκολία.
Οι
εσκεμμένες παρεμβάσεις στον ίδιο τον γενετικό κώδικα, πέρα από τις σημερινές
μεθόδους που επιτρέπουν την εισαγωγή ξένων γονιδίων, θα ήταν χρήσιμες στη
βιομηχανία τεχνολογίας, τονίζουν οι ερευνητές.
In the new study,
the researchers working with E. coli swapped a codon and eliminated its natural
stop sign that terminates protein production. The new genome enabled the
bacteria to resist viral infection by limiting production of natural proteins
used by viruses to infect cells. Isaacs — working with Marc Lajoie of Harvard,
Alexis Rovner of Yale, and colleagues — then converted the "stop"
codon into one that encodes new amino acids and inserted it into the genome in
a plug-and-play fashion.
Η
αλλαγή της γλώσσας του DNA, για παράδειγμα, θα προστάτευε τα καλλιεργούμενα
μικρόβια από επιθέσεις ιών, οι οποίες προκαλούν σήμερα προβλήματα στη
φαρμακευτική βιομηχανία.
Επιπλέον,
η χρήση μικροβίων που χρειάζονται σπάνια αμινοξέα, τα οποία δεν απαντώνται στη
φύση, θα εμπόδιζε την απόδρασή τους και τον πολλαπλασιασμό τους στο περιβάλλον.
Η
παρέμβαση στον γενετικό κώδικα, τέλος, θα επέτρεπε τη σύνθεση εντελώς νέων
πρωτεϊνών, όπως για παράδειγμα φαρμάκων τυλιγμένων με αλυσίδες πολυμερών, έτσι
ώστε να αυξάνεται η διάρκεια ζωής τους στην κυκλοφορία του αίματος.
Όπως
σχολίασε ο επικεφαλής της μελέτης δρ Τσερτς, οι νέες μελέτες «ίσως μας
προσφέρουν μια εντελώς νέα χημική εργαλειοθήκη για τη βιοτεχνολογική παραγωγή».

Δεν υπάρχουν σχόλια:
Δημοσίευση σχολίου